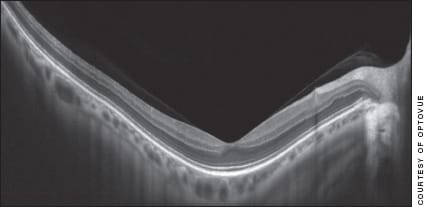

What the New Era of SD-OCT Brings to Retina Care
A look at the state of the art in technology and patient management.
By S.K. Steven Houston, III, MD
Optical coherence tomography's non-invasive, in vivo “biopsies” of the retina have led to much advancement in the diagnosis, management and understanding of retinal disease, and serves as an invaluable tool in the clinical setting. From its introduction two decades ago1, OCT continues to evolve both in hardware and software applications. With these updates and advancements, ophthalmologists are faced with an ever-changing scene of cutting-edge technology, making it difficult to sort through the various platforms, software analysis tools, study and treatment protocols and everyday clinical applications. This feature will discuss spectral-domain OCT's current diagnostic and disease management applications, and review the new developments on the horizon.
Evolving Technology
Time-domain OCT (TD-OCT) revolutionized posterior segment imaging by providing details of morphology not captured by prior technologies. OCT uses a light source directed toward the retina and a reference arm leading to backscattered light that is detected as an interference pattern. The device produces up to 400 A-scans per second, resulting in a B-scan image with an axial resolution of 8-10 microns.2,3 Image resolution is hindered by the movable reference mirror which requires longer scanning times, thus introducing a window for patient movement and lower quality images.
To improve on the limitations of TD-OCT, spectral-domain OCT (SD-OCT), or Fourier-domain, was developed using a high-speed spectrometer to measure light frequency changes simultaneously, and not requiring a moving reference mirror. These advancements allowed for the rapid acquisition of up to 40,000 A-scans per second, with an increase in axial resolution to 5-6 microns.4 SD-OCT improved signal-to-noise ratios with faster scanning rates, limiting patient movements. Enhanced imaging capabilities led to better image quality, including improved differentiation of retinal layers such as the RPE/Bruch's membrane complex, photoreceptor inner segment/outer segment (IS/OS) junction and the external limiting membrane.

Figure 1. AMD patient. (A) Subretinal fluid imaged with TD-OCT prior to treatment with anti-VEGF agents. (B) TD-OCT image after treatment shows resolution of fluid. However, this image is not able to delineate the neovascular membrane clearly or subtle fluid. The image also does not distinguish the IS/OS junction or ELM. (C) SD-OCT image delineates the neovascular membrane clearly, as well as the intact IS/OS junction and ELM. (D) SD-OCT image showing subtle fluid overlying the neovascular membrane.
SD-OCT also allowed for three-dimensional imaging, as well as software programs providing segmentation and thickness maps to further aid in the clinical setting. With faster acquisition times, as well as eye-tracking technologies in some platforms, consistent, reproducible images are obtained that can be followed over time.
Ever since its commercial release, OCT has been used to aid in the diagnosis and management of many retinal diseases, including age-related macular degeneration, diabetic macular edema, cystoid macular edema secondary to Irvine-Gass, and both branch and central retinal vein occlusions. Additionally, with the study of anti-vascular endothelial growth factor inhibitors, TD-OCT was assessed along with visual acuity to determine treatment efficacy. In fact, SDOCT has not been used in any large, prospective, clinical trials published to date. As a result, not only is it difficult to compare images and data among the various SD-OCT platforms, but also to apply the findings from clinical trials that used TD-OCT.
Diagnosing and Treating AMD
The treatment of AMD has been revolutionized with the use of anti-angiogenic inhibitors, with OCT aiding in the diagnosis and management. The earliest trials on the use of anti-VEGF agents for AMD (ANCHOR, MARINA)5,6 use OCT to monitor central macular thickness, finding that patients not only had significant improvements in visual acuity, but also on the thickness measurements. These studies used TD-OCT, with later studies (PrONTO)7 basing retreatment criteria on OCT findings and yielding similar visual acuity results as those in MARINA and ANCHOR, but with fewer injections. Re-treatment features include intraretinal or subretinal fluid indicating choroidal neovascular membrane (CNVM) activity.
SD-OCT permits the earlier detection of subtle retinal changes, and may allow for the earlier identification of CNVM activity and decision to treat. Earlier detection and treatment may result in significant gains in vision. In the context of clinical trials using TD-OCT, potential gains using SD-OCT have not been validated, but the ongoing CATT study includes one arm that compares variable OCT-guided schedules with TD-OCT and SD-OCT to determine whether the enhanced image quality and detection of subtle disease activity actually reflects improvement in visual outcomes.
Improved segmentation maps with SD-OCT also offer tools for the ophthalmologist in AMD management, with retinal thickness maps that can be reliably and consistently reproduced, as well as RPE maps to dynamically follow changes in drusen over time. These software additions provide invaluable quantitative data on a patient's treatment response, which can easily be followed and compared.

Figure 2. (A) TD-OCT shows significant intraretinal cystic edema. (B) SD-OCT of the same patient allows for the visualization of the IS/OS and ELM indicating that visual acuity may be maintained after treatment. (C) TD-OCT after treatment, with improvement in fluid, but inability to differentiate retinal layers or IS/OS and ELM. (D) SD-OCT also after treatment at a later date shows improvement in fluid, and visualization of IS/OS and ELM.
| OCT for General Ophthalmology |
|---|
| OCT is no longer reserved for a retina practice — it can be useful for comprehensive ophthalmologists as well. TDOCT provides a fast, reliable screening examination of findings observed on ophthalmic examination. This may include evaluation of diabetics for CSME, conversion of dry macular degeneration to the wet form and vitreoretinal interface disorders. Using OCT, ophthalmologists can refer in a timely manner to the appropriate specialist, or observe for changes that may necessitate referral. OCT may also enhance preoperative assessment for cataract surgery to identify subtle retinal pathologies that may limit final visual acuity outcomes. SD-OCT may provide additional information about visual potential based on the appearance of the IS/OS junction and the ELM. Postoperative evaluation with OCT may identify early complications such as CME, thus allowing the surgeon to institute prompt treatment. Finally, patients with an unexplained decrease in vision may benefit from an OCT to determine subtle retinal changes such as retinal atrophy or disruption of the normal retinal architecture. OCT offers enhanced imaging of the retina, providing important information for ophthalmologists in many practice settings. |
Macular Edema
Diabetic macular edema has also seen a shift in treatment algorithms as anti-VEGF agents have shown significant benefits in visual outcome. OCT has allowed for quantitative measurements of central macular thickness to follow a patient's response to treatment. Multiple clinical trials, including protocols by the DRCR Network,8 the READ-29 and the BOLT study,10 used TD-OCT in the diagnosis and management of DME, showing the efficacy of anti-VEGF agents with prompt or deferred laser by significantly improving visual acuity and OCT central macular thickness. However, OCT retinal thickness measurements do not always correlate with visual acuity, as patients without fluid may often have worse vision than another patient with significant macular edema.
SD-OCT has played an integral role in the evaluation of the retinal microstructure, notably the ELM and IS/OS junction. Studies have shown that disruption of these complexes is significantly correlated with worsened visual acuity. As a result, SD-OCT with enhanced image quality may provide additional information on the retinal microstructure in addition to gross pathologic changes, both of which may contribute to visual function and guide further treatment.
Like DME and AMD, cystoid macular edema from retinal vascular pathologies (BRVO, CRVO) and Irvine-Gass benefits from OCT in the diagnosis and management. Anti-VEGF agents have been used with success in the treatment of CME (BRAVO, CRUISE)11,12 with improvement of visual acuity and central macular thickness as measured by OCT. As a result, OCT allows for quantitative and consistent evaluation of patients with CME, and helps to guide the treatment with anti-VEGF agents. Like studies on other disease entities, it remains to be determined whether the use of SDOCT will contribute to improved outcomes via earlier or improved detection of retinal morphologic changes.

Figure 3. Central serous retinopathy SD-OCT with fine detail not possible by TD-OCT.
Future Technological Developments
OCT provides detailed information on the retinal micro structure down to the RPE, with SD-OCT providing enhanced image resolution over TD-OCT. However, both technologies use infrared light sources in the 800 nm wavelength. As a result, both of these image modalities have difficulty imaging structures below the RPE, as the melanin inhibits the penetration of light. With many macular diseases thought to have the choroid as the site of pathology, future imaging seeks to provide a more detailed assessment of these sub-RPE structures, namely the choroid and the choriocapillaris. Two modified SD-OCT technologies seek to address these current limitations.
• Long-wavelength and EDI. OCT that uses light at longer wavelengths (>1000 nm) than current SD-OCT devices allows enhanced light penetration for visualization of structures below the RPE.
Enhanced-depth imaging (EDI) uses current SD-OCT platforms to selectively image these deeper structures. Also called “flip-flop” OCT, the OCT device is moved closer to the eye to obtain an inverted image, where the tightly focused illumination falls on the choroid and sclera, placing these structures closest to the zero-delay to enhance the imaging of them.13 As a result, EDI-OCT allows for imaging of structures below the RPE and measures choroidal thickness. Idiopathic central serous chorioretinopathy (ICSC) has been investigated with EDI-OCT, identifying that patients have increased choroidal thickness, a finding consistent with the proposed role of RPE hyperpermeability in this disease entity.
Further studies may continue to define the pathophysiologic mechanisms responsible for the subretinal fluid in ICSC. Enhanced imaging of sub-RPE structures may also provide valuable information regarding diseases such as VKH, choroidal melanoma, uveitis, as well as more information regarding the structural alterations of PEDs and type 1 CNVMs in AMD. These imaging modalities may even allow for early detection of CNVMs in dry AMD, as well as define other unknown or unidentified choroidal diseases.
Figure 4. An -18 D myope imaged by SD-OCT, again with subtle details visible.
• Photoacoustic and Doppler OCT. These technologies on the horizon will assess retinal and choroidal blood flow, and polarization-sensitive OCT to determine the health of the RPE. Photoacoustic ophthalmoscopy (POAM) is an imaging modality that can be coupled with SD-OCT and consists of pulsed illuminating laser light followed by the detection of the photoacoustic waves generated by this light absorption by the retina.14
Potential uses of this technology combined with SDOCT include imaging of the retinal vasculature, measurement of oxygen saturation in retinal vessels, as well as the metabolic rate of oxygen, which may prove useful in patients with retinal diseases secondary to ischemia. Determination of local and global parameters of oxygen metabolism may aid in the early diagnosis and management of entities such as diabetes. Doppler OCT also offers the ability to image the retinal and choroidal vasculature in a three-dimensional network without the need for a contrast agent.
Doppler OCT takes advantage of the phase changes of flowing blood cells to create segmentation maps of the vasculature against the surrounding static structures.15 More work is needed on this technology before accurate measurements of total blood flow and quantitative velocities are able to be obtained. However, Doppler OCT and POAM have the potential to provide quantitative information regarding the retinal and choroidal vasculature that may offer insight into many disease processes with unknown significance in diagnosis and management in the clinical setting.
• PS-OCT. Finally, polarization-sensitive OCT uses polarized light illumination followed by detection via polarization channels of the backscattered light. The unique property of depolarization exhibited by RPE cells allows PSOCT to visualize and segment this vital structure. SD-OCT and autofluorescence have been investigated to monitor RPE health and subsequent geographic atrophy in dry AMD, with PS-OCT potentially offering a combination of these two techniques.16 PS-OCT may provide quantitative measurement of geographic atrophy, as well as information regarding the health of the RPE along the borders of the atrophic areas. We await further developments and studies using PS-OCT and anticipate its use in the management of patients with RPE abnormalities, notably dry AMD.
• Intraoperative applications. In addition to the development of new OCT imaging modalities, current clinical SD-OCT platforms are being modified for use in the operative setting. Several device manufacturers have developed commercially available portable units or prototypes that may be used to image patients during operative procedures. Whether handheld or mounted in the operating microscope, intraoperative OCT imaging may provide invaluable information for the surgeon regarding precise anatomy and localization of pathology. Additional work is being performed on real-time OCT imaging via a microscope mounted device,17 which may allow the surgeon to visualize enhanced images in real time to aid in surgical procedures such as membrane peeling.
Conclusion
OCT technology has revolutionized ophthalmic imaging and continues to undergo advancements and improvements. Faster imaging, greater axial resolution and enhanced image quality has accompanied the shift from TD-OCT to SD-OCT. With this shift has come uncertainty, as practitioners must interpret studies using prior technologies and apply to the current clinical setting. SD-OCT, as well other imaging modalities offer exciting possibilities in the diagnosis, understanding, and management of retinal and choroidal diseases. However, with increasing healthcare costs and the significant overhead required for the necessary hardware and software, further studies are needed to determine whether these technologic advancements correlate with improved patient outcomes. OM
References
1. Huang D, Swanson EA, Lin CP, et al. Optical coherence tomography. Science 1991; 254: 1178-1181.
2. Hee MR, Izatt JA, Swanson EA, et al. Optical coherence tomography of the human retina. Arch Ophthalmol 1995;113:325-332.
3. Puliafito CA, Hee MR, Lin CP, et al. Imaging of macular diseases with optical coherence tomography. Ophthalmology 1995;102:217-229.
4. Fujimoto JG. Optical coherence tomography for ultrahigh resolution in vivo imaging. Nat Biotechnol 2003;21:1361-1367.
5. Rosenfeld PJ, Brown DM, Heier JS, et al. Ranibizumab for neovascular age-related macular degeneration. N Engl J Med 2006;355:1419-1431.
6. Brown DM, Kaiser PK, Michels M, et al. Ranibizumab versus verteporfin for neovascular age-related macular degeneration. N Engl J Med 2006;355:1432-1444.
7. Fung AE, Lalwani GA, Rosenfeld PJ, et al. An optical coherence tomography-guided, variable dosing regimen with intravitreal ranibizumab (Lucentis) for neovascular age-related macular degeneration. Am J Ophthalmol 2007;143:566-583.
8. Elman MJ, Aiello LP, Beck RW, et al. Randomized trial evaluating ranibizumab plus prompt or deferred laser or triamcinolone plus prompt laser for diabetic macular edema. Ophthalmology 117:1064-1077 e1035.
9. Nguyen QD, Shah SM, Khwaja AA, et al. Two-year outcomes of the ranibizumab for edema of the mAcula in diabetes (READ-2) study. Ophthalmology 117:2146-2151.
10. Michaelides M, Kaines A, Hamilton RD, et al. A prospective randomized trial of intravitreal bevacizumab or laser therapy in the management of diabetic macular edema (BOLT study) 12-month data: report 2. Ophthalmology 117:1078-1086 e1072.
11. Campochiaro PA, Hafiz G, Shah SM, et al. Ranibizumab for macular edema due to retinal vein occlusions: implication of VEGF as a critical stimulator. Mol Ther 2008;16:791-799.
12. Brown DM, Campochiaro PA, Singh RP, et al. Ranibizumab for macular edema following central retinal vein occlusion: six-month primary end point results of a phase III study. Ophthalmology 117:1124-1133 e1121.
13. Spaide RF, Koizumi H, Pozzoni MC. Enhanced depth imaging spectral-domain optical coherence tomography. Am J Ophthalmol 2008;146:496-500.
14. Zhang X, Zhang HF, Puliafito CA, Jiao S. Simultaneous in vivo imaging of melanin and lipofuscin in the retina with photoacoustic ophthalmoscopy and autofluorescence imaging. J Biomed Opt 16:080504.
15. Geitzenauer W, Hitzenberger CK, Schmidt-Erfurth UM. Retinal optical coherence tomography: past, present and future perspectives. Br J Ophthalmol 95:171-177.
16. Pircher M, Hitzenberger CK, Schmidt-Erfurth U. Polarization sensitive optical coherence tomography in the human eye. Prog Retin Eye Res.
17. Ehlers JP, Tao YK, Farsiu S, Maldonado R, Izatt JA, Toth CA. Integration of a spectral domain optical coherence tomography system into a surgical microscope for intraoperative imaging. Invest Ophthalmol Vis Sci 52:3153-3159.
| S.K. Steven Houston, III, MD, is an ophthalmology resident at Bascom Palmer Eye Institute in Miami. He is actively engaged in retinal research in the Ocular Oncology lab headed by Timothy G. Murray, MD. He can be reached at shouston@med.miami.edu. |








